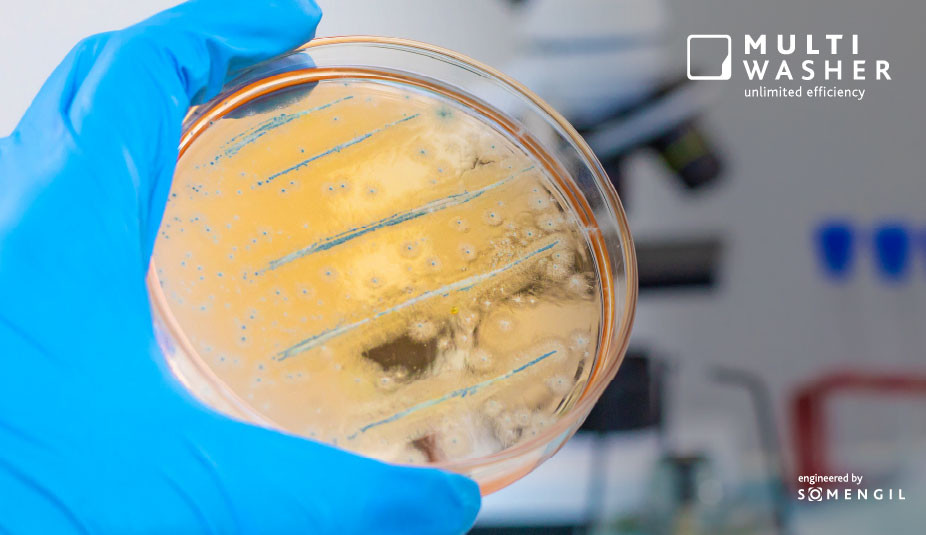
Biofilmes na cozinha profissional: o que são, por que preocupam e como vencê-los (sem drama)

Lavagem Industrial / Artigos
Biofilmes na cozinha profissional: o que são, por que preocupam e como vencê-los (sem drama)
Na cozinha profissional, superfícies plásticas acumulam biofilmes que protegem microrganismos e comprometem a higiene. Protocolos estratégicos e lavadoras industriais de cabine tornam a limpeza mais segura, rápida e padronizada.
7 Minutos de leitura
7 Minutos de leitura
2025-12-17 12:48:54
Biofilmes são comunidades de microrganismos que se fixam a uma superfície e se envolvem numa “armadura” pegajosa — a matriz EPS (substâncias poliméricas extracelulares). Invisíveis a olho nu, eles adoram ambientes úmidos, nutrientes e microfrestas onde a limpeza passa “por cima”. Resultado: persistem, voltam e podem contaminar alimentos mesmo depois de higienizações aparentemente corretas.
O tamanho do problema (sem rodeios)
Dados do Centro de Controle e Prevenção de Doenças Americano (CDC) informam que dentro de um biofilme, as bactérias ficam muito mais difíceis de eliminar: os estudos mostram tolerância até 1.000 vezes maior a saneantes e antimicrobianos quando comparadas às mesmas bactérias livres (plânctonicas). É por isso que o “limpa e passa o sanitizante” nem sempre resolve quando há biofilme instalado.
Na indústria de alimentos, agentes como Listeria monocytogenes aproveitam biofilmes para persistir em linhas e áreas de apoio, ressurgindo em recontaminações intermitentes. Cozinhas de hotel, catering e centrais de produção precisam tratar biofilme como risco operacional — e não como exceção.
Por que os plásticos pedem atenção redobrada
Utensílios e componentes plásticos (tábuas de corte, caixas/caixotes, GN plásticos, cestos, rodízios, gaxetas e arruelas) são críticos por um motivo simples: micro-riscos e desgaste aumentam a rugosidade, e superfícies mais rugosas aderem mais microrganismos e favorecem biofilmes. Em outras palavras, a cada risco de faca, queda ou lavagens abrasivas, o plástico vai ficando mais “hospitaleiro” para as colônias.
Há anos a literatura técnica aponta que tábuas plásticas usadas em serviço de alimentação são superfícies ideais para formação de biofilme, especialmente quando já apresentam marcas de uso. É uma combinação de material + textura + umidade que pede protocolo específico.
Como lidar com biofilmes de forma profissional
A lógica é desmontar a casa do biofilme antes de desinfetar. Em prática:
1. Limpeza que rompe a matriz
Detergência eficaz (alcalina, surfactantes) e, quando indicado, detergentes enzimáticos para degradar proteínas/amido do EPS. O objetivo é expor as células; só então o sanitizante atua de verdade.
2. Ação mecânica + tempo + temperatura + química
O famoso “TACT” precisa estar calibrado para o tipo de sujidade e superfície. Turbulência/impacto hidráulico, contato suficiente e temperaturas controladas fazem diferença diária (e na auditoria).
3. Padronização de ciclos e validação
Defina ciclos por família de itens (plásticos texturizados, GN, cestos, caixas). Valide com ATP e swabs ambientais nos pontos críticos (drenos, borrachas, cantos de caixas, rodízios.
4. Equipamento que entrega reprodutibilidade
Lavadoras industriais de cabine ajudam a tirar o processo da variabilidade manual: mesma sequência de ação mecânica + tempo + temperatura + produto, carga após carga. isso reduz recontaminação por manuseio e devolve mais rápido utensílios — inclusive plásticos — prontos para uso. É aqui que soluções como a Multiwasher (Somengil) entram de forma estratégica: ciclos configuráveis, registro de parâmetros e fluxo linear para manter a operação rodando com previsibilidade, especialmente em alta demanda.
Checklist rápido (para hoje)
- Mapeie pontos quentes de biofilme: plásticos riscados, gaxetas, rodízios, drenagens.
- Separe famílias de itens plásticos e ajuste TACT específico.
- Introduza detergente enzimático nas rotinas de choque.
- Use cabine industrial para padronizar e registrar.
- Valide com ATP e rotas de swab; reaja a desvios.
_________________________________________________________________________________________
FAQ – Biofilmes (SEO)
1) O que é biofilme?
É uma comunidade microbiana aderida a uma superfície, envolta por uma matriz EPS que protege e dificulta a remoção. Aparece em aço inox, borrachas e, com frequência, em plásticos usados na cozinha profissional.
2) Por que biofilmes são perigosos?
Porque tornam os microrganismos muito mais tolerantes a saneantes: até 1.000× em comparação ao estado livre. Isso aumenta o risco de recontaminações recorrentes e eventos de segurança de alimentos.
3) Onde eles surgem com mais frequência na cozinha?
Em superfícies plásticas com riscos e porosidade (tábuas, caixas, cestos, GN), em gaxetas, rodízios, drenagens e cantos de difícil acesso. Rugosidade superficial é um fator crítico para adesão e maturação do biofilme.
4) Como remover biofilmes de forma efetiva?
Primeiro rompa a matriz com detergência adequada (incluindo enzimáticos quando indicado), depois desinfete. Combineação mecânica, tempo, temperatura e química — e valide com ATP/swab.
5) Lavadora de cabine ajuda mesmo com itens plásticos?
Sim. A cabine padroniza TACT, reduz manipulação e entrega ciclos reprodutíveis. Equipamentos de alto desempenho — como a Multiwasher, da Somengil — permitem configurar e registrar parâmetros por família de itens, favorecendo o controle de biofilmes no dia a dia.
6) Listeria e biofilme: devo me preocupar?
Sim. Listeria monocytogenes é conhecida por persistir em ambientes de processamento e pode se abrigar em biofilmes. Programas ambientais contínuos são recomendados.
7) Com que frequência rever meu protocolo?
Em alta rotatividade (hotéis, eventos, catering), revise mensalmente parâmetros, itens plásticos danificados e resultados de ATP/swab; faça “choques” enzimáticos periódicos e substitua plásticos excessivamente riscados.
Você também pode gostar

Lavagem Industrial / Artigos
Indústria de Pré-Congelados: crescimento acelerado e oportunidades estratégicas
A indústria de pré-congelados cresce impulsionada por conveniência e escala, tornando eficiência operacional e padronização fatores críticos de c...
Publicado em 2026-05-04

Lavagem Industrial / Artigos
Uma questão química: como melhorar o controle de qualidade através da lavagem
O controle de qualidade é uma atividade essencial para o dia-a-dia das empresas, tendo impacto direto nos resultados da mesma. Mas não é possível...
Publicado em 2021-10-14























 Portugal
Portugal United Kingdom
United Kingdom United States
United States France
France Spain
Spain Germany
Germany Romania
Romania Italy
Italy Czech Republic
Czech Republic Finland
Finland Hungary
Hungary Slovakia
Slovakia Greece
Greece Lithuania
Lithuania South Korea
South Korea Russia
Russia Saudi Arabia
Saudi Arabia Poland
Poland Brasil
Brasil Hebrew
Hebrew